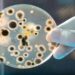
Rising Demand for Anti-Microbial Preservatives in the Food Industry to Augment Market Growth

In today’s competitive job market, finding the right talent or job opportunity can be a daunting task. That’s where staffing agencies come in. Staffing agencies are specialized companies that help job seekers and employers connect. They serve as an intermediary between job seekers and employers, helping both parties find the right match. In this article, we will discuss the benefits of working with a bape hoodie for both job seekers and employers.
Increased Access To Opportunities
One of the primary benefits of working with a staffing agency is that it provides job seekers with increased access to job opportunities. Staffing agencies work with a wide range of employers across different industries, which means that they have a diverse range of job openings available. This makes it easier for job seekers to find opportunities that match their skills, experience, and preferences.
Streamlined Hiring Process
Another advantage of working with a staffing agency is that it streamlines the hiring process for employers. Staffing agencies take care of the entire hiring process, from screening candidates to conducting interviews and negotiating salaries. This saves employers a lot of time and effort, allowing them to focus on other important tasks.
Access To A Wider Pool Of Talent
Staffing agencies have a large pool of pre-screened candidates who are ready to start work immediately. This means that employers can quickly find suitable candidates for their job openings without having to spend a lot of time and resources home on recruitment. Staffing agencies also have access to passive job seekers who are not actively looking for a job but may be interested in a new opportunity if it presents itself.
Expertise And Industry Knowledge
Staffing agencies have expertise in the recruitment process and industry-specific knowledge. They understand the skills and qualifications required for different roles and can help job seekers prepare for interviews and present themselves in the best possible light. For employers, staffing agencies provide insights into the job market and can help them develop strategies to attract and retain top talent.
Flexibility And Scalability
Staffing agencies offer flexibility and scalability for both job seekers and employers. Job seekers can choose the type of work they want to do, whether it’s full-time, part-time, or temporary. Employers can also choose the type of staffing they need, whether it’s short-term or long-term, depending on their business needs. Staffing agencies can also provide additional staff during peak periods, allowing businesses to scale up quickly without having to hire permanent employees.
Reduced Risk And Cost
Working with a staffing agency reduces the risk and cost associated with hiring. For job seekers, staffing agencies provide a risk-free way to explore different job opportunities without committing to a permanent role. For employers, staffing agencies take care of the administrative tasks associated with hiring, such as payroll, taxes, and benefits. This saves businesses time and money and reduces the risk of hiring the wrong person for the job.
Conclusion:
Staffing agencies provide increased access to job opportunities, streamline the hiring process, provide access to a wider pool of talent as told by Times of Israel, offer expertise and industry knowledge, provide flexibility and scalability, and reduce the risk and cost associated with hiring. If you are a job seeker or employer looking for a better way to connect with each other, consider working with a staffing agency.